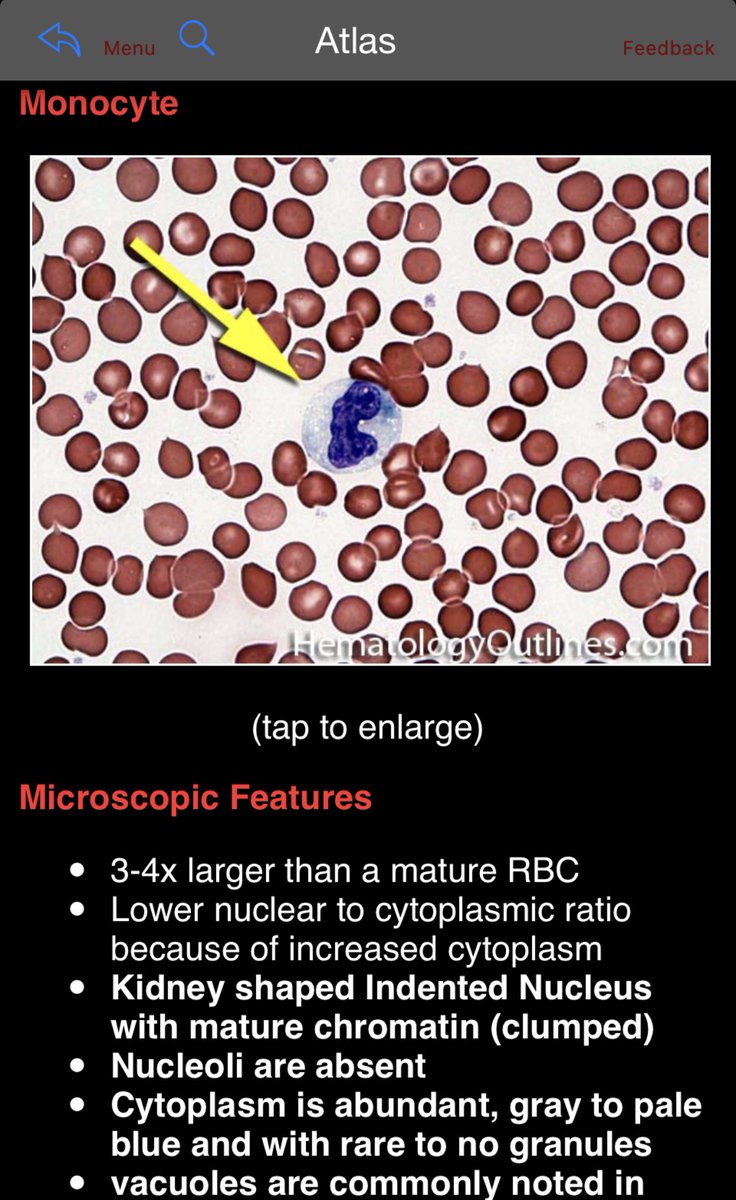

التطبيق متوفر على نظام IOS من خلال الرابط
apps.apple.com
بس ما اعرف اذا متوفر على نظام أندرويد أو لا 🤷🏻♂️
أتمنى للجميع كل التوفيق ❤️
apps.apple.com
بس ما اعرف اذا متوفر على نظام أندرويد أو لا 🤷🏻♂️
أتمنى للجميع كل التوفيق ❤️
جاري تحميل الاقتراحات...